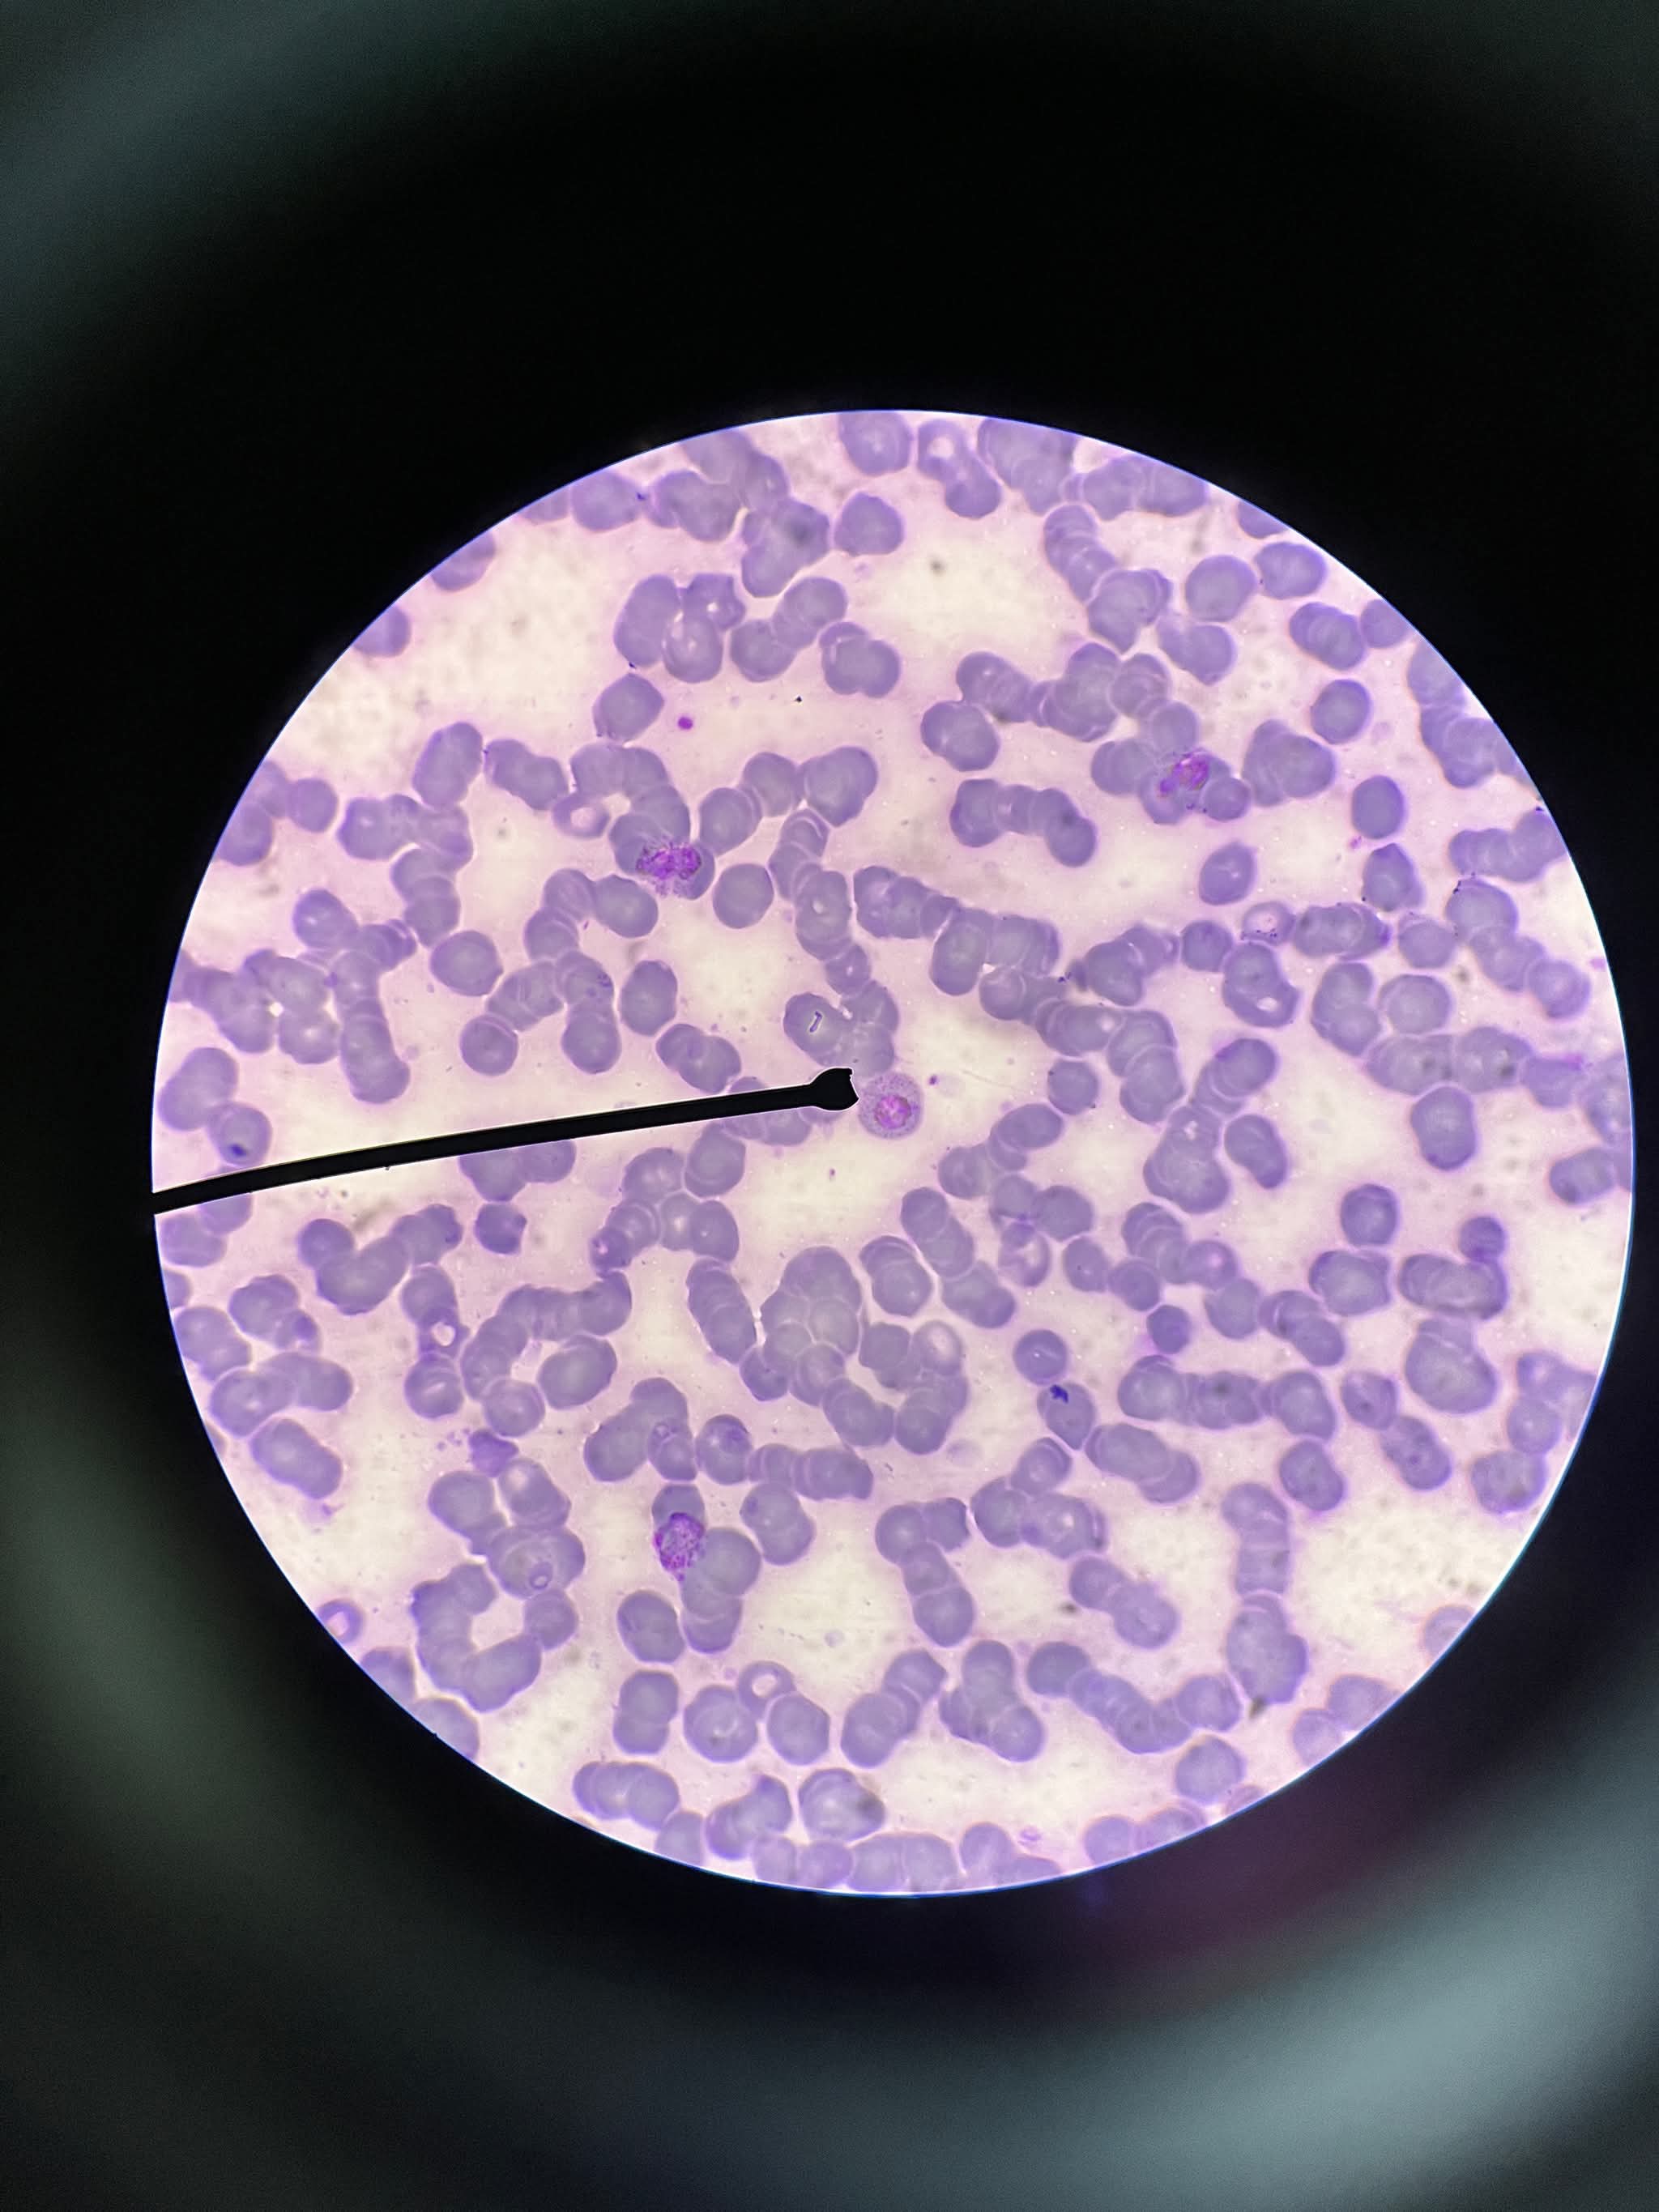

COMPILATION OF PARASITES NAMES AND STAGES
1/90
There's no tags or description
Looks like no tags are added yet.
Name | Mastery | Learn | Test | Matching | Spaced | Call with Kai |
|---|
No analytics yet
Send a link to your students to track their progress
91 Terms

Capillaria philippinensis, Ova

Hookworm, L3 Filariform Larva

Strongyloides stercoralis, L3 Filariform Larva

Enterobius vermicularis, Ova
Oxyuris vermicularis, Ova

Trichinella spiralis, encysted larva

Trichuris trichiura, Unembryonated Ova

Trichuris trichiura, Unembryonated Ova (wet mount)

Ascaris lumbricoides, Corticated, Fertilized Ova (wet mount)

Ascaris lumbricoides, Corticated, Unfertilized Ova (wet mount)

Hookworm, L3 Filariform Larva

Onchocerca volvulus, microfilaria

Adult

Hookworm, L3 Filariform Larva

Trichuris trichiura, Adult, Female

Enterobius vermicularis/ Oxyuris vermicularis, Adult, Female

Hookworm,
Hookworm, L1 Rhabditiform Larva

Capillaria philippinesis, Female adult

Ancylostoma caninum,
Ancylostoma caninum, Male adult

Ascaris lumbricoides, Decorticated, Fertilized Ova

Ascaris lumbricodes,
Ascaris lumbricodes, Embryonated Ova (wet mount)

Jsoamma
Entamoeba histolytica, Trophozoite stage

Entamoeba coli, Trophozoite stage

Mxoanaoak
Entamoeba histolytica, Cyst stage

Entamoeba histolytica, Cyst stage

Entamoeba coli, Cyst stage

lodameoba butschlii, Trophozoite stage

lodamoeba butschlii, Cyst stage

Endolimax nana, Cyst stage

Balantidium coli, Trophozoite stage

Balantidium coli, Cyst stage

Plasmodium falciparum, Ring form

Plasmodium falciparum, Gametocyte

Plasmodium vivax, Ring form

Plasmodium vivax, Immature Schizont

Plasmodium vivax, Mature Schizont
Plasmodium vivax, Gametocyte

Plasmodium ovale, Developing Trophozoite

Plasmodium ovale, Immature Schizont

Plasmodium ovale, Gametocyte

Plasmodium ovale, Gametocyte

Paragonimus westermani, Adult Worm (in Lung Section)

Paragonimus westermani, Ova

Schistosoma japonicum, Female Adult Worm

Schistosoma japonicum, Male Adult Worm

Schistosoma japonicum, Adult Worms in Copula

Schistosoma japonicum, Ova

Schistosoma japonicum, Miracidium

Schistosoma japonicum, Cercariae

Fasciola spp. , Sporocyst

Fasciola hepatica, Ova

Fasciola hepatica, Adult Worm

Fasciola gigantica, Ova

Fasciola gigantica, Adult Worm

Heterophyes heterophyes, Adult Worm

Metagonimus yokogawai, Adult Worm


Taenia spp., Egg/Ova (HPO)

Taenia solium, Scolex

Taenia solium, Immature segment

Taenia solium, Mature segment

Taenia solium, Gravid segment

Taenia solium, Cysticercus larva

Taenia solium, Cysticercus larva in muscle

Taenia saginata, Scolex

Taenia saginata, Immature segment

Taenia saginata, Mature segment

Taenia saginata, Gravid segment

Hymenolepis nana, Egg/Ova

Hymenolepis diminuta, Egg/Ova

Hymenolepis diminuta, Scolex

Hymenolepis diminuta, Mature segment

Dibothriocephalus latus (formerly Diphyllobothrium latum), Egg/Ova (LPO)

Dibothriocephalus latus (formerly Diphyllobothrium latum), Egg/Ova (HPO)

Dibothriocephalus latus (formerly Diphyllobothrium latum), Immature segment

Dibothriocephalus latus (formerly Diphyllobothrium latum), Mature segment

Dibothriocephalus latus (formerly Diphyllobothrium latum), Gravid segment

Dipylidium caninum, Scolex

Dipylidium caninum, Mature segment

Dipylidium caninum, Gravid segment

Giardia lamblia, Trophozoite Stage

Giardia lamblia, Trophozoite Stage

Giardia lamblia, Cyst Stage

Giardia lamblia, Cyst Stage

Giardia lamblia, Cyst Stage

Chilomastix mesnili, Trophozoite Stage

Chilomastix mesnili, Trophozoite Stage

Chilomastix mesnili, Cyst Stage

Chilomastix mesnili, Cyst Stage

Trichomonas vaginalis, Trophozoite Stage

Leishmania donovani, Promastigote Stage

Trypanosoma rhodesiense, Trypomastigote Stage